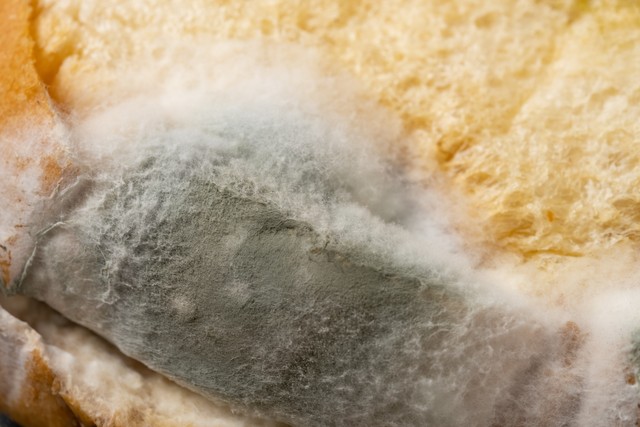

近日,一场由“酸汤子”引发的家庭悲剧震惊全国,夺走了多条生命,也让一个陌生的名词——“米酵菌酸”毒素再一次进入了公众视野。这起事件不仅是一个家庭的悲剧,更是对所有人家庭饮食安全的一次严厉警告。那么,酸汤子究竟是什么?为何如此致命?我们日常饮食中又隐藏着哪些类似风险?本文将为您一一揭晓。
一、酸汤子:一种传统但风险暗藏的食物
酸汤子,是流行于中国东北地区(尤其是辽宁、吉林)的一种传统发酵面食。它的制作工艺独特:
1. 原料:通常以玉米面为主,也可用其他谷物。
2. 发酵过程:将玉米面在水中浸泡,进行自然发酵,这个过程短则数日,长则一两周。期间,依靠空气中落入的天然菌种进行发酵,产生酸味,从而形成带有特殊风味的湿面团。
3. 成型:发酵好的面团通过挤压成条状,直接落入沸水中煮熟,搭配汤卤食用。
其独特的风味正源于这种开放式的“自然发酵”。然而,成也萧何,败也萧何。正是这种未经控制的发酵环境,为致命毒素的滋生埋下了祸根。
二、夺命元凶:米酵菌酸毒素的产生机制
导致酸汤子中毒的罪魁祸首是 “米酵菌酸”。这种毒素并非食物本身所有,而是在特定条件下由污染的微生物产生的。
1. 毒素来源:米酵菌酸主要由两种细菌产生:椰毒假单胞菌和 唐菖蒲伯克霍尔德菌。这两种细菌在自然界广泛存在,尤其在霉变的谷物(如玉米、小米、糯玉米)、久泡的木耳、银耳以及薯类制品中容易滋生。
2. 产生条件:
温度和湿度:在26°C至28°C的温暖潮湿环境中,这些细菌会迅速繁殖。
发酵环境:酸汤子制作过程中的长时间浸泡和发酵,恰好为这些细菌提供了理想的温床。如果原料本身已经受潮霉变,或者在发酵过程中被这些细菌污染,它们就会大量繁殖并产生致命的米酵菌酸毒素。
3. 毒素特性:米酵菌酸是小分子毒素,极其耐高温。即使用100℃的沸水长时间煮沸或用高压锅蒸煮,也无法将其破坏。这意味着,一旦食物中产生了这种毒素,日常的烹饪加热根本无法去除其毒性。
三、警惕!这些食物同样存在风险
酸汤子事件并非孤例。米酵菌酸中毒在国内外都时有发生,以下这些常见食物是高风险品类,需要格外警惕:
1. 发酵的玉米面制品:除了酸汤子,北方一些地区的“臭碴子”、“格格豆”等类似发酵玉米面食品,风险等同。
2. 久泡的黑木耳、银耳:这是近年来导致多起中毒事件的“头号杀手”之一。许多人习惯将干木耳或银耳泡发后隔夜使用,这是非常危险的行为。在长时间泡发过程中,如果环境温度适宜,椰毒假单胞菌极易污染并产生毒素。建议:冷水泡发不超过4小时,热水泡发不超过2小时,切勿隔夜。
3. 湿米粉、河粉、米线:这些产品在生产过程中如果卫生控制不严,或存放时间过长,也可能被污染。购买时需选择正规厂家,并注意冷藏和保质期。
4. 薯类制品(如红薯粉、马铃薯粉):如果原料储存不当发生霉变,加工成的淀粉类制品也可能携带风险。
5. 自酿谷类发酵酒:家庭自制的发酵酒类,如果工艺控制不当,也存在潜在风险。
核心风险特征:所有风险食物都涉及富含淀粉的原料,在温暖、潮湿的环境下,经历了长时间的存放或发酵。
四、家庭饮食安全:预防为先,识别为要
面对这种“隐形杀手”,预防是唯一且最有效的手段。
(一)预防措施:杜绝源头
1. 谨慎对待家庭自制发酵谷物食品:除非对传统工艺有绝对把握并能严格控制卫生条件,否则不建议家庭自行制作酸汤子这类高风险发酵食品。不要为了“传统风味”而冒生命危险。
2. 坚决不食用变质、霉变食物:对于任何有异味、发霉、长毛的粮食、坚果和薯类,要坚决丢弃,切勿切掉坏部分继续食用,因为毒素可能已扩散至看似完好的部分。
3. 科学泡发木耳、银耳:
即泡即吃:吃多少泡多少。
控制时间:参照上述建议时间。
冰箱泡发:如需提前准备,务必密封后放入冰箱冷藏泡发。
丢弃粘稠物:泡发后如发现表面黏糊糊、质地软烂无弹性,请立即丢弃。
4. 购买正规产品:购买湿米粉、河粉等产品时,选择包装完好、标签清晰、有SC认证的正规产品,并注意冷藏储存,在保质期内食用。
5. 保持厨房卫生:用于处理食物的砧板、刀具、容器等要经常清洗消毒,保持干燥,避免交叉污染。
(二)尽早识别:中毒症状与体征
米酵菌酸中毒潜伏期短则30分钟,长则12小时。一旦在食用可疑食物后出现以下症状,必须高度警惕:
消化道症状:上腹不适、恶心、呕吐、腹胀、腹痛等(与普通肠胃炎类似,极易误诊)。
神经系统症状:头晕、乏力、精神萎靡、嗜睡、意识模糊、抽搐等。
多器官衰竭迹象:这是最危险的阶段。毒素会攻击肝、脑、肾等多个脏器,导致黄疸(皮肤、眼睛变黄)、血尿、少尿甚至无尿、休克,死亡率极高。
关键点:如果多人同食一种食物后,几乎同时出现类似症状,特别是伴有神经精神症状时,应立刻联想到食物中毒,并立即就医。
五、紧急处理:争分夺秒,生死时速
一旦怀疑米酵菌酸中毒,每一秒都至关重要。
1. 立即停止食用:马上停止食用可疑食物。
2. 紧急呼救,立刻就医:立即拨打120急救电话!不要自行在家观察或尝试土方。明确告诉医生怀疑是“米酵菌酸中毒”以及食用了何种食物,这能为医生诊断和抢救提供最关键的方向。
3. 保留样本:将吃剩的可疑食物用干净容器装好,密封冷冻保存,一并带给医生或疾控部门进行检测,这是查明真相的重要证据。
4. 对症处理(在医生指导下或等待救援时):
如果患者清醒,可尝试催吐,但若已出现严重呕吐或意识障碍,则禁止催吐,防止窒息。
注意保暖,保持患者呼吸道通畅。
重要提示:目前对米酵菌酸中毒尚无特效解毒药,医院的治疗主要以早期洗胃、清肠(清除未被吸收的毒素)、血液净化(清除已进入血液的毒素)以及对症支持治疗(保肝、护脑、维持生命体征)为主。因此,早期识别和迅速送医是挽救生命的唯一希望。